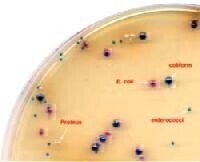
New Chromogenic Uti Medium is Launched: New Clarity Agar Improves Differentiation of Uti Pathogens

Laboratory products
New Chromogenic Uti Medium is Launched: New Clarity Agar Improves Differentiation of Uti Pathogens
Apr 05 2007
Chromogenic culture media are used increasingly to aid in the diagnosis of UTIs. Since several micro-organisms may be present in a specimen, the use of chromogens helps to distinguish between colonies of different species on a culture plate. However, some chromogenic UTI media do not differentiate enterococci and coliforms by colour. Others exhibit poor recovery of Staphylococcus aureus. Although this species is only responsible for 0.5 6% of UTIs, its presence in urine may be an early indication of a pre-existing bacteraemia and so should not be overlooked1.
Oxoid Chromogenic UTI Clarity Agar allows good growth of the main UTI pathogens, whilst preventing swarming of Proteus species. The new, specific chromogens used in this medium, together with the transparent nature of the medium, allow good differentiation between species, including coliforms (which have dark blue/purple colonies) and enterococci (which have blue/turquoise colonies). It also allows improved recovery of Staphylococcus aureus and correct presumptive identification of Citrobacter freundii, which can be problematic with some other media.
With easily interpreted results available in just 16-24 hours, Oxoid Chromogenic UTI Clarity Agar helps a presumptive diagnosis to be made promptly, allowing patients to receive appropriate treatment at an early opportunity. This may help to improve recovery and reduce complications of UTIs, such as pyelonephritis and bacteraemia.
Digital Edition
Lab Asia Dec 2025
December 2025
Chromatography Articles- Cutting-edge sample preparation tools help laboratories to stay ahead of the curveMass Spectrometry & Spectroscopy Articles- Unlocking the complexity of metabolomics: Pushi...
View all digital editions
Events
Jan 21 2026 Tokyo, Japan
Jan 28 2026 Tokyo, Japan
Jan 29 2026 New Delhi, India
Feb 07 2026 Boston, MA, USA
Asia Pharma Expo/Asia Lab Expo
Feb 12 2026 Dhaka, Bangladesh